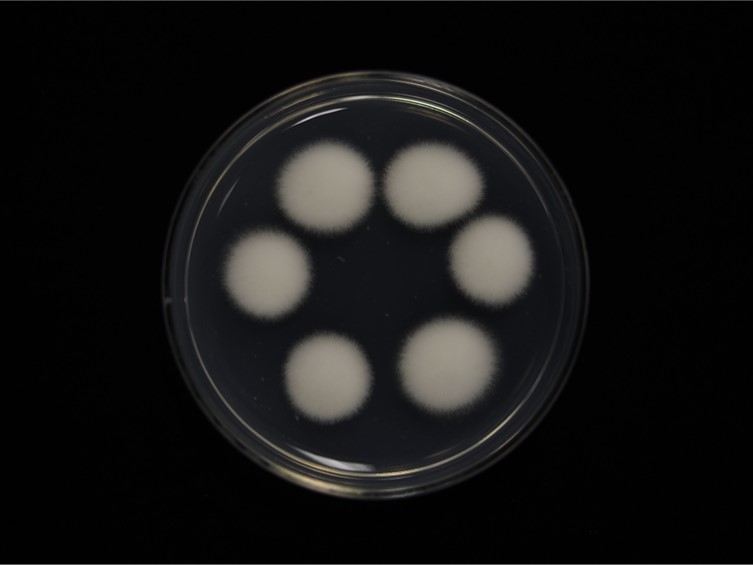

Holotype:
JAPAN.
Habitat:
Leaf litter
Host:
Lepidopteran larva and pupa.
Description:
Specimens were found in the leaf litter. Hosts are lepidopteran pupae.  Stromata (rarely solitary) more usually forming aggregations of 2–8 stromata, cylindrical or clavate, 1–4 cm tall, fleshy, almost fragile fertile part at the upper half of the stroma.
Stromata (rarely solitary) more usually forming aggregations of 2–8 stromata, cylindrical or clavate, 1–4 cm tall, fleshy, almost fragile fertile part at the upper half of the stroma.  Perithecia superficial to pseudoimmersed, ovoid, 300–400 × 180–270 µm.
Perithecia superficial to pseudoimmersed, ovoid, 300–400 × 180–270 µm.  Asci cylindrical, hyaline, 150–300 × 2–3 µm. Ascospores whole, hyaline, bola-shaped, 280–300 × 1–2 µm.
Asci cylindrical, hyaline, 150–300 × 2–3 µm. Ascospores whole, hyaline, bola-shaped, 280–300 × 1–2 µm.
Culture characteristics:
Colonies on PDA grow fast attaining a diam of 40–70 mm within 14 d at 25 °C. Sporulation begins after 4 d, white at first, then becoming creamish yellow and powdery with age. Phialides 4.5–6.2 × 2–3.2 μm, consisting of swollen basal portion tapering into a long neck. Conidia cylindrical to slightly curved (kidney shaped), smooth-walled, hyaline, 4.5–6.5 × 2.1–2.4 μm.
Colonies on PDA grow fast attaining a diam of 40–70 mm within 14 d at 25 °C. Sporulation begins after 4 d, white at first, then becoming creamish yellow and powdery with age. Phialides 4.5–6.2 × 2–3.2 μm, consisting of swollen basal portion tapering into a long neck. Conidia cylindrical to slightly curved (kidney shaped), smooth-walled, hyaline, 4.5–6.5 × 2.1–2.4 μm.
Other Available strains
TBRC 3891 , TBRC 4464 , TBRC 6860 , TBRC 8294 , TBRC 8327 , TBRC 8358Reference:
Luangsa-ard JJ, Hywel-Jones NL, Manoch Let al. (2005). On the relationships of Paecilomyces sect. Isarioidea species. Mycological Research109: 581–589.
Luangsa-ard JJ, Tasanathai K, Mongkolsamrit S et al. (2007). Isaria tenuipes Peck. In: Atlas of invertebrate-pathogenic fungi of Thailand Volume 1 . National Center for Genetic Engineering and Biotechnology, National Science and Technology Development Agency: 54–55.
Samson RA (1974). Paecilomyces and some allied Hyphomycetes. Studies in Mycology6: 49–52.
Species |
Strain |
Compound |
Pubchem CID |
Biological activity |
Reference |
|---|---|---|---|---|---|
| Cordyceps tenuipes | TBRC 6860 | Isariotin A (1) | 159931 | Antimicrobial acitvity against S. aureus; Antimicrobial acitvity against E. coli | Haritakun et al. 2007 |
| Cordyceps tenuipes | TBRC 6860 | Isariotin B (2) | 159931 | Antimicrobial acitvity against S. aureus; Antimicrobial acitvity against E. coli | Haritakun et al. 2007 |
| Cordyceps tenuipes | TBRC 6860 | Isariotin C (3) | 159931 | Antimicrobial acitvity against S. aureus; Antimicrobial acitvity against E. coli | Haritakun et al. 2007 |
| Cordyceps tenuipes | TBRC 6860 | Isariotin D (4) | 159931 | Antimicrobial acitvity against S. aureus; Antimicrobial acitvity against E. coli | Haritakun et al. 2007 |
| Cordyceps tenuipes | TBRC 4464 | Beauvericin (5) | 159931 | Antimicrobial acitvity against S. aureus; Antimicrobial acitvity against E. coli | Nilanonta et al. 2000 |
| Cordyceps tenuipes | TBRC 4464 | Beauvericin A (6) | 159931 | Antimicrobial acitvity against S. aureus; Antimicrobial acitvity against E. coli | Nilanonta et al. 2000 |
| Cordyceps tenuipes | TBRC 8327 | Isarotin E (7) | 159931 | Antimicrobial acitvity against S. aureus; Antimicrobial acitvity against E. coli | Bunyapaiboonsri et al. 2009 |
| Cordyceps tenuipes | TBRC 8327 | Isarotin F (8) | 159931 | Antimicrobial acitvity against S. aureus; Antimicrobial acitvity against E. coli | Bunyapaiboonsri et al. 2009 |
| Cordyceps tenuipes | TBRC 8327 | TK-57-164A (9) | 159931 | Antimicrobial acitvity against S. aureus; Antimicrobial acitvity against E. coli | Bunyapaiboonsri et al. 2009 |
| Cordyceps tenuipes | TBRC 3891 | Isarotin G (10) | 159931 | Antimicrobial acitvity against S. aureus; Antimicrobial acitvity against E. coli | Bunyapaiboonsri et al. 2011 |
| Cordyceps tenuipes | TBRC 8294 | Isarotin H (11) | 159931 | Antimicrobial acitvity against S. aureus; Antimicrobial acitvity against E. coli | Bunyapaiboonsri et al. 2011 |
| Cordyceps tenuipes | TBRC 8358 | Isarotin I (12) | 159931 | Antimicrobial acitvity against S. aureus; Antimicrobial acitvity against E. coli | Bunyapaiboonsri et al. 2011 |
| Cordyceps tenuipes | TBRC 8358 | Isarotin J (13) | 159931 | Antimicrobial acitvity against S. aureus; Antimicrobial acitvity against E. coli | Bunyapaiboonsri et al. 2011 |
| Cordyceps tenuipes | TBRC 8358 | Tenuipyrone (14) | 159931 | Antimicrobial acitvity against S. aureus; Antimicrobial acitvity against E. coli | Asai et al. 2012 |
| Cordyceps tenuipes | TBRC 8358 | Cephalosporolide B (15) | 159931 | Antimicrobial acitvity against S. aureus; Antimicrobial acitvity against E. coli | Asai et al. 2012 |
| Cordyceps tenuipes | TBRC 8358 | Cephalosporolide F (16) | 159931 | Antimicrobial acitvity against S. aureus; Antimicrobial acitvity against E. coli | Asai et al. 2012 |
| Cordyceps tenuipes | TBRC 8358 | Paecilomycine A (17) | 159931 | Antimicrobial acitvity against S. aureus; Antimicrobial acitvity against E. coli | Kikuchi et al. 2004 |
| Cordyceps tenuipes | TBRC 8358 | Paecilomycine B (18) | 159931 | Antimicrobial acitvity against S. aureus; Antimicrobial acitvity against E. coli | Kikuchi et al. 2004 |
| Cordyceps tenuipes | TBRC 8358 | Paecilomycine C (19) | 159931 | Antimicrobial acitvity against S. aureus; Antimicrobial acitvity against E. coli | Kikuchi et al. 2004 |
|
Strain |
ITS | LSU | RPB1 | RPB2 | TEF1 |
|---|---|---|---|---|---|
| TBRC 7265 | MF140741 | MF140707 | MF140776 | MF140800 | MF140827 |
| TBRC 7266 | MF140742 | MF140708 | MF140777 | MF140801 | MF140828 |
| TBRC 7267 | MF140740 | MF140706 | MF140775 | MF140799 | MF140826 |